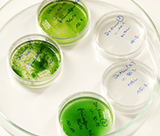

Municipal Solid Waste : New solution
Municipal Solid waste is looming into a major problem world-over. With the increased appetite for consumerism, increase in purchase capability and wide availability of consumable items, change in life styles and quality of life, the solid

Petroleum Waste in refineries
In the petroleum refining process, the heavier hydrocarbon chains such as paraffins and asphaltenes are problematic. When processing this heavier hydrocarbon in the form of sludge, sludge minus the sediments.

GREY WATER purification
“More than half of humanity will be living with water shortages, depleted fisheries and polluted coastlines within 50 years because of a worldwide water crisis, warns a United Nations report.

ZERO ENERGY SCALE CONTROL TECHNOLOGIES
Sustech Aqualizers are designed for removing or reducing Chlorine, iron, lead, mercury and soluble heavy metals. They are also used for Prevention and Elimination.

Special Media for Filtration
Arsenic occurring naturally in groundwater is classified as a human carcinogen (prone to cancer of the bladder, lungs, skin, kidney, liver, and prostate) by the International Agency for Research

Waste Plastics and polymers to Fuel
The world is facing the problem of disposal of waste plastics. The ease of manufacture and the abundant availability of plastics in all wakes of life, have created a situation where the useless and waste plastics from the abandoned electronics.

Biomass to Energy
Algae to Diesel technology
Algae occupies vast areas of water bodies. Algae grown in lakes spoils the waters even though algae is an excellent de-pollutant for atmospheric emissions.
STEPSONIC algae control
Ponds and lakes are mostly characterized by stagnant water. Within these waters algae may occur in undesirable concentrations. Algal growth within a pond or lake may cause bad odors, unclear and unattractive looking water.

Agricultural Waste
The kitchen waste such as vegetables, fruits, poultry, meat, wood, leaves, tree branches, paper, cooking oil etc., fall under this category.






